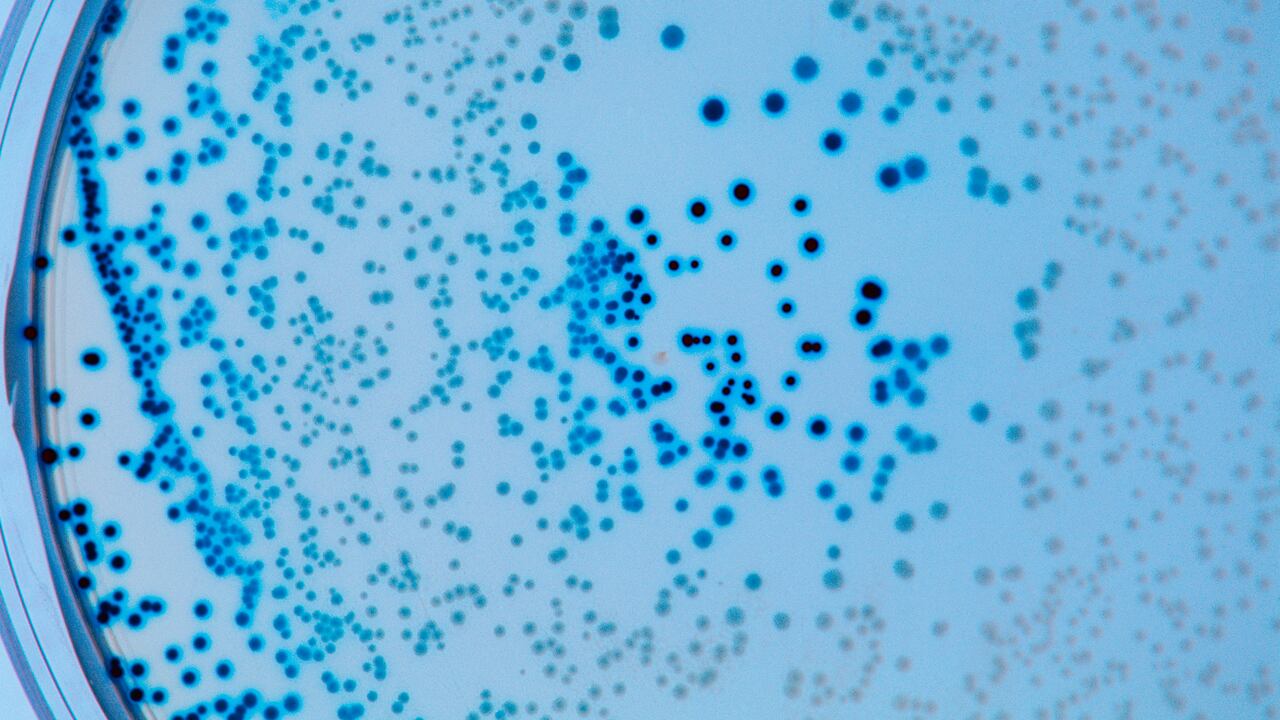
Foto de referencia sobre bacterias

La E. coli es un tipo de bacteria que se encuentra en el ambiente, incluyendo el agua, los alimentos y en los intestinos de personas y animales. Hay muchos tipos de E. coli que son inofensivos, pero otros pueden causar enfermedades graves en los seres humanos, una premisa que tiene en alerta a las autoridades en Estados Unidos.
La Administración de Alimentos y Medicamentos de Estados Unidos (FDA) anunció una investigación sobre un brote de zanahorias enteras y pequeñas que podrían haber estado contaminadas con la bacteria E. coli productora de toxina la shiga, brote reportado hace algunas semanas en el país norteamericano.
La investigación se produce tras un retiro voluntario de varias marcas de zanahorias emitido por Grimmway Farms el 16 de noviembre después de que los Centros para el Control y la Prevención de Enfermedades (CDC) informaran que estos productos podrían estar relacionados con un brote mortal de infecciones por E. coli.

El pasado 26 de noviembre, 4Earth Farms de Commerce, California, retiró del mercado varias marcas de Organic Vegetable Medley, Conventional Vegetable Medley y Organic Whole Carrots.
En total, 39 personas resultaron infectadas y 15 fueron hospitalizadas en 18 estados después de consumir zanahorias orgánicas enteras o de miniatura vendidas por Grimmway Farms, informó el domingo los Centros para el Control y la Prevención de Enfermedades (CDC).
El 22 de noviembre, por lo menos 19 personas en Minnesota han enfermado por E. coli, en un incidente vinculado a un retiro a escala nacional de más de 75.751 kilogramos (167.000 libras) de carne molida potencialmente contaminada, informaron autoridades federales de salud.
La empresa Wolverine Packing Co., con sede en Detroit, retiró la carne esta semana, cuando las autoridades agrícolas estatales de Minnesota reportaran múltiples casos de infección y encontraran que una muestra del producto dio positivo para E. coli O157:H7, que puede causar infecciones potencialmente letales.
4Earth Farms, LLC. Recalls Organic and Conventional Vegetable Medleys and Organic Whole Carrots, Containing Grimmway Farms Carrots, Because of Possible Health Risk https://t.co/vywRC0OXux pic.twitter.com/KeytFUbBof
— U.S. FDA Recalls (@FDArecalls) November 29, 2024
La FDA aseguró en un informe que los minoristas, distribuidores y consumidores deben seguir los consejos de limpieza y manipulación segura de la FDA y tener especial cuidado al limpiar y desinfectar cualquier superficie y recipiente que pueda haber estado en contacto con estos productos para reducir el riesgo de contaminación cruzada.
Los síntomas pueden incluir (entre otros) calambres estomacales, diarrea, vómitos excesivos, fiebre de más de 39 °C (102 °F) y/o mareos, que suelen comenzar entre tres y cuatro días después de ingerir la bacteria, aunque el período de incubación puede ser de entre 24 horas y 10 días.

Según la FDA, hay productos específicos que han sido retirados del mercado tras el brote de E. coli en zanahorias recientemente:
- Zanahorias orgánicas enteras de Grimmway Farms en presentación de 1 libra, comercializadas por Kennedy Produce.
- Medley de vegetales orgánicos de Wild Harvest, con un peso de 12 oz, distribuido por Albert’s Organics y UNFI.
- Medley de vegetales Marketside en tamaños de 12 oz y 32 oz, así como el Stir Fry Medley, disponible en formato de 12 oz que se encuentran en Walmart.
- Medley de vegetales orgánicos de 4Earth Farms en una presentación de 12 oz, que se encuentra en Sprouts Farmers se ofrece el según informa la FDA.